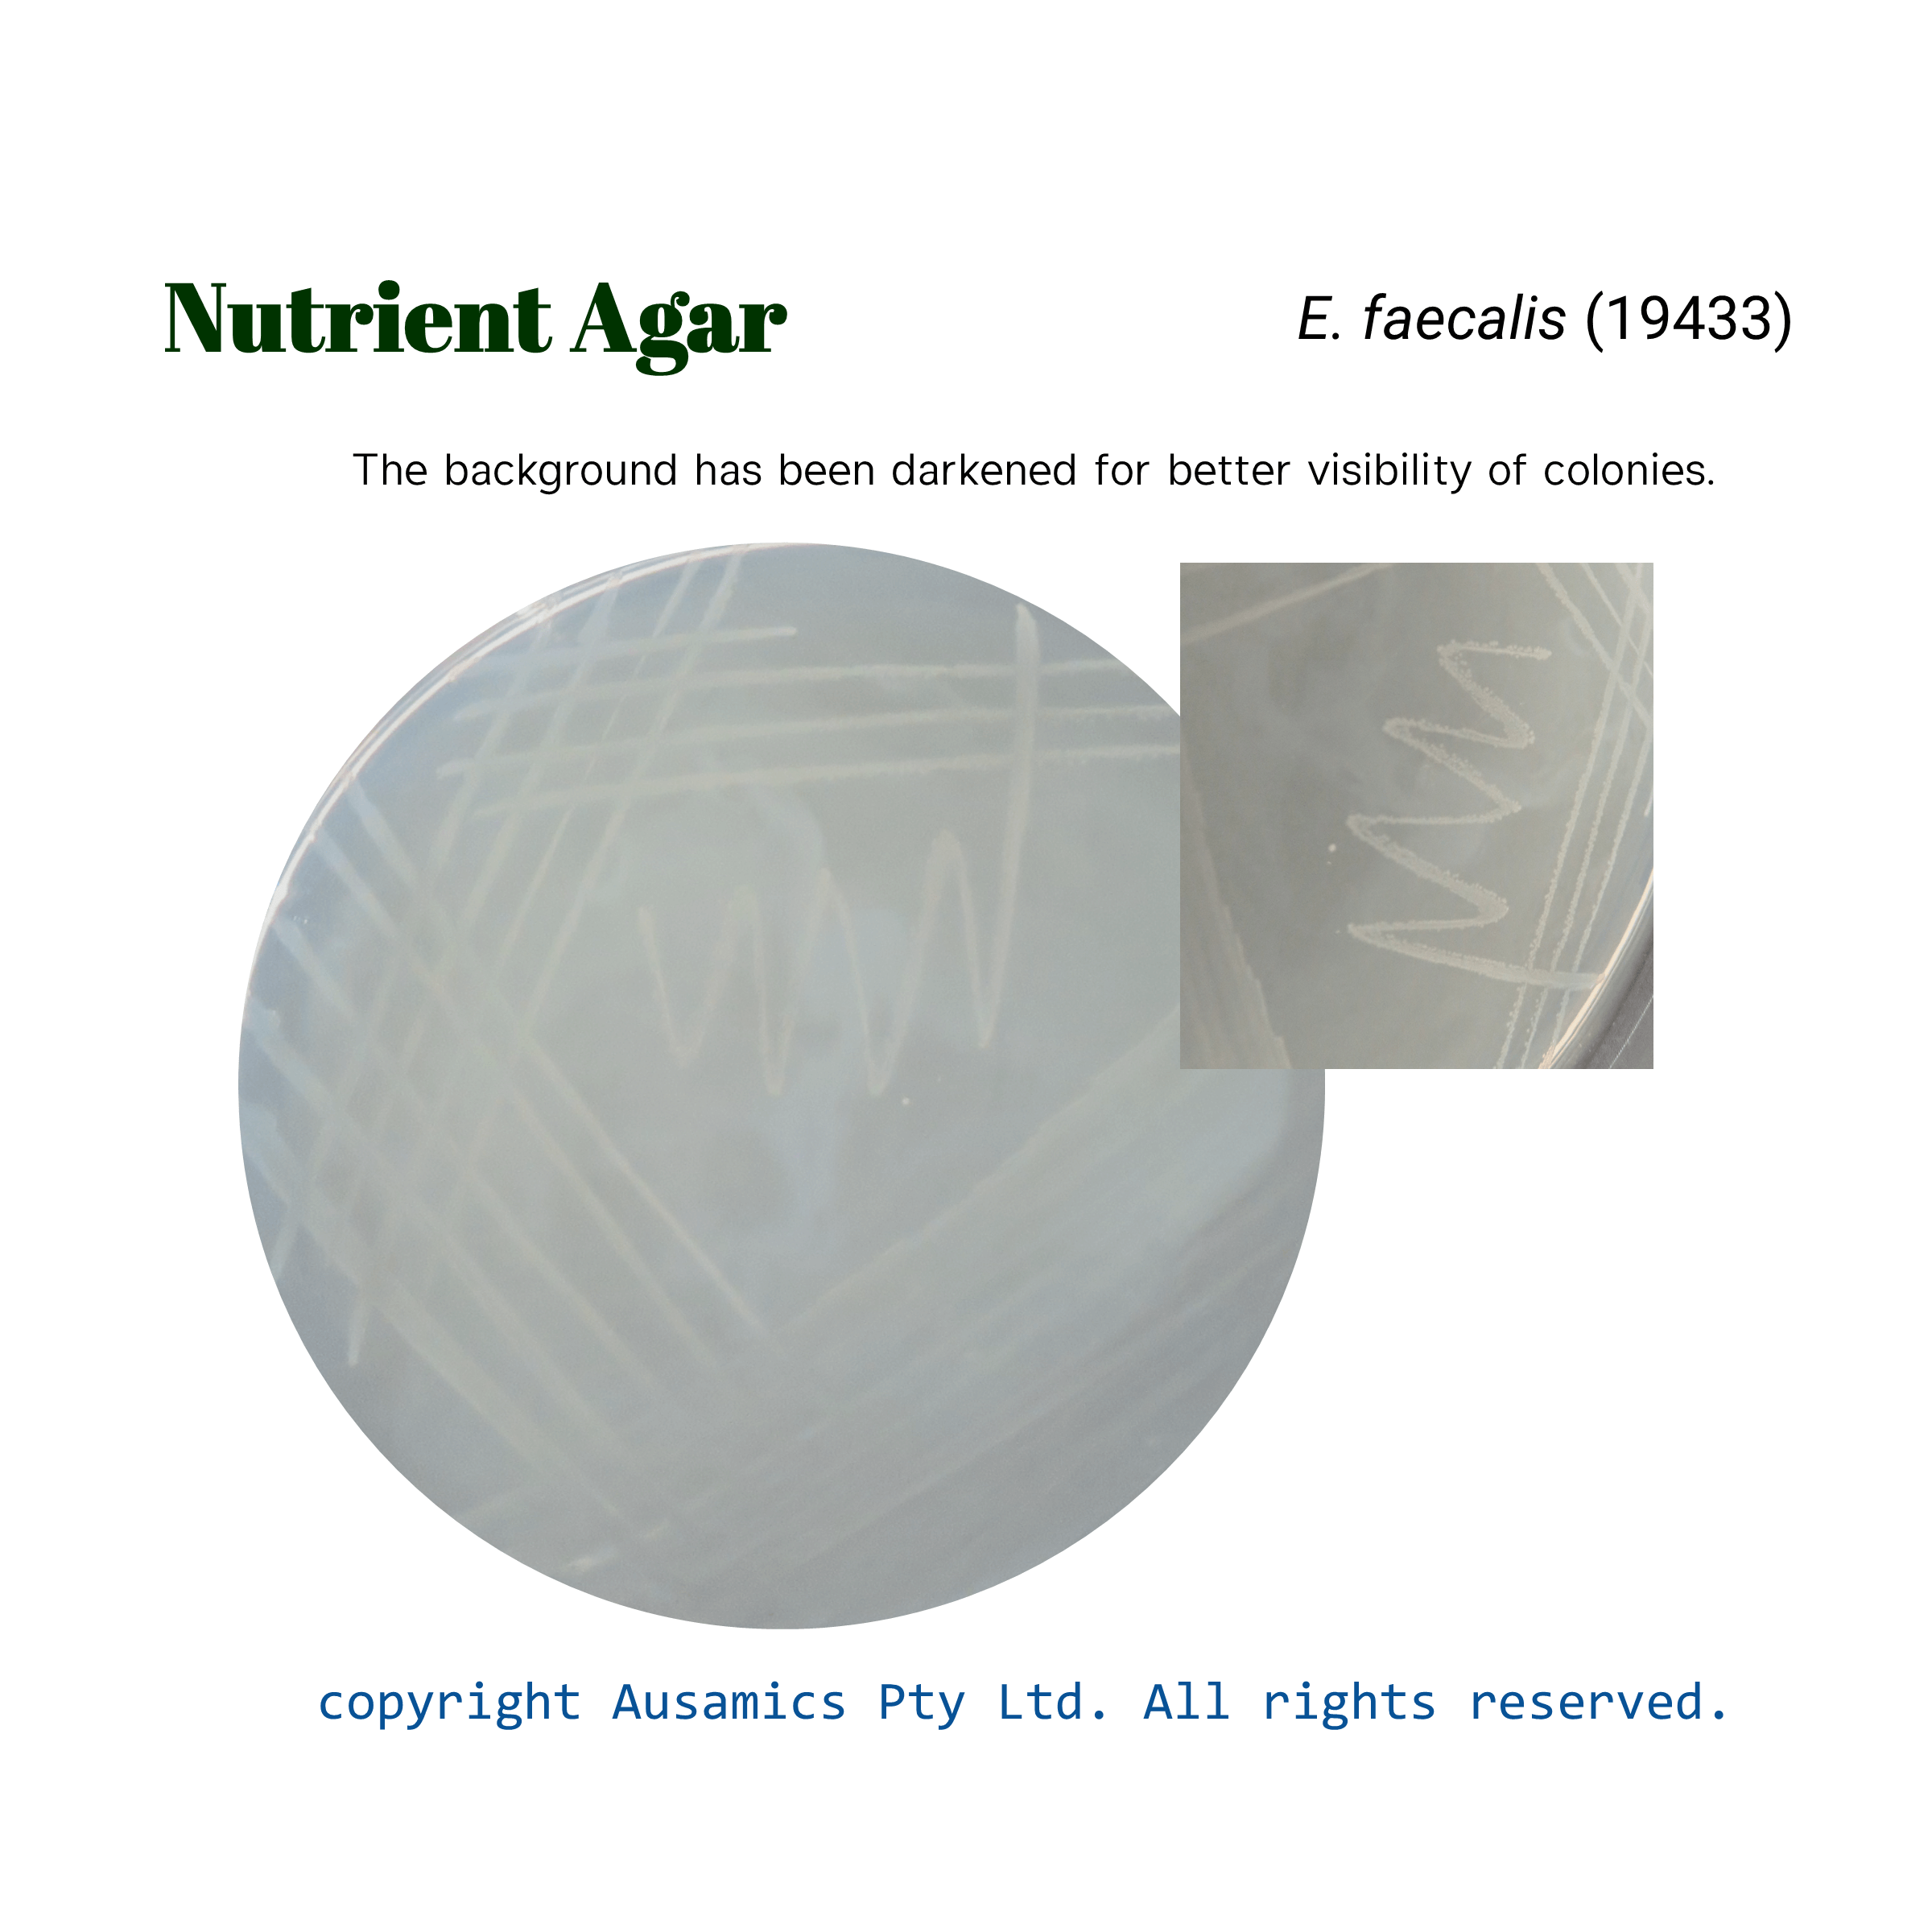
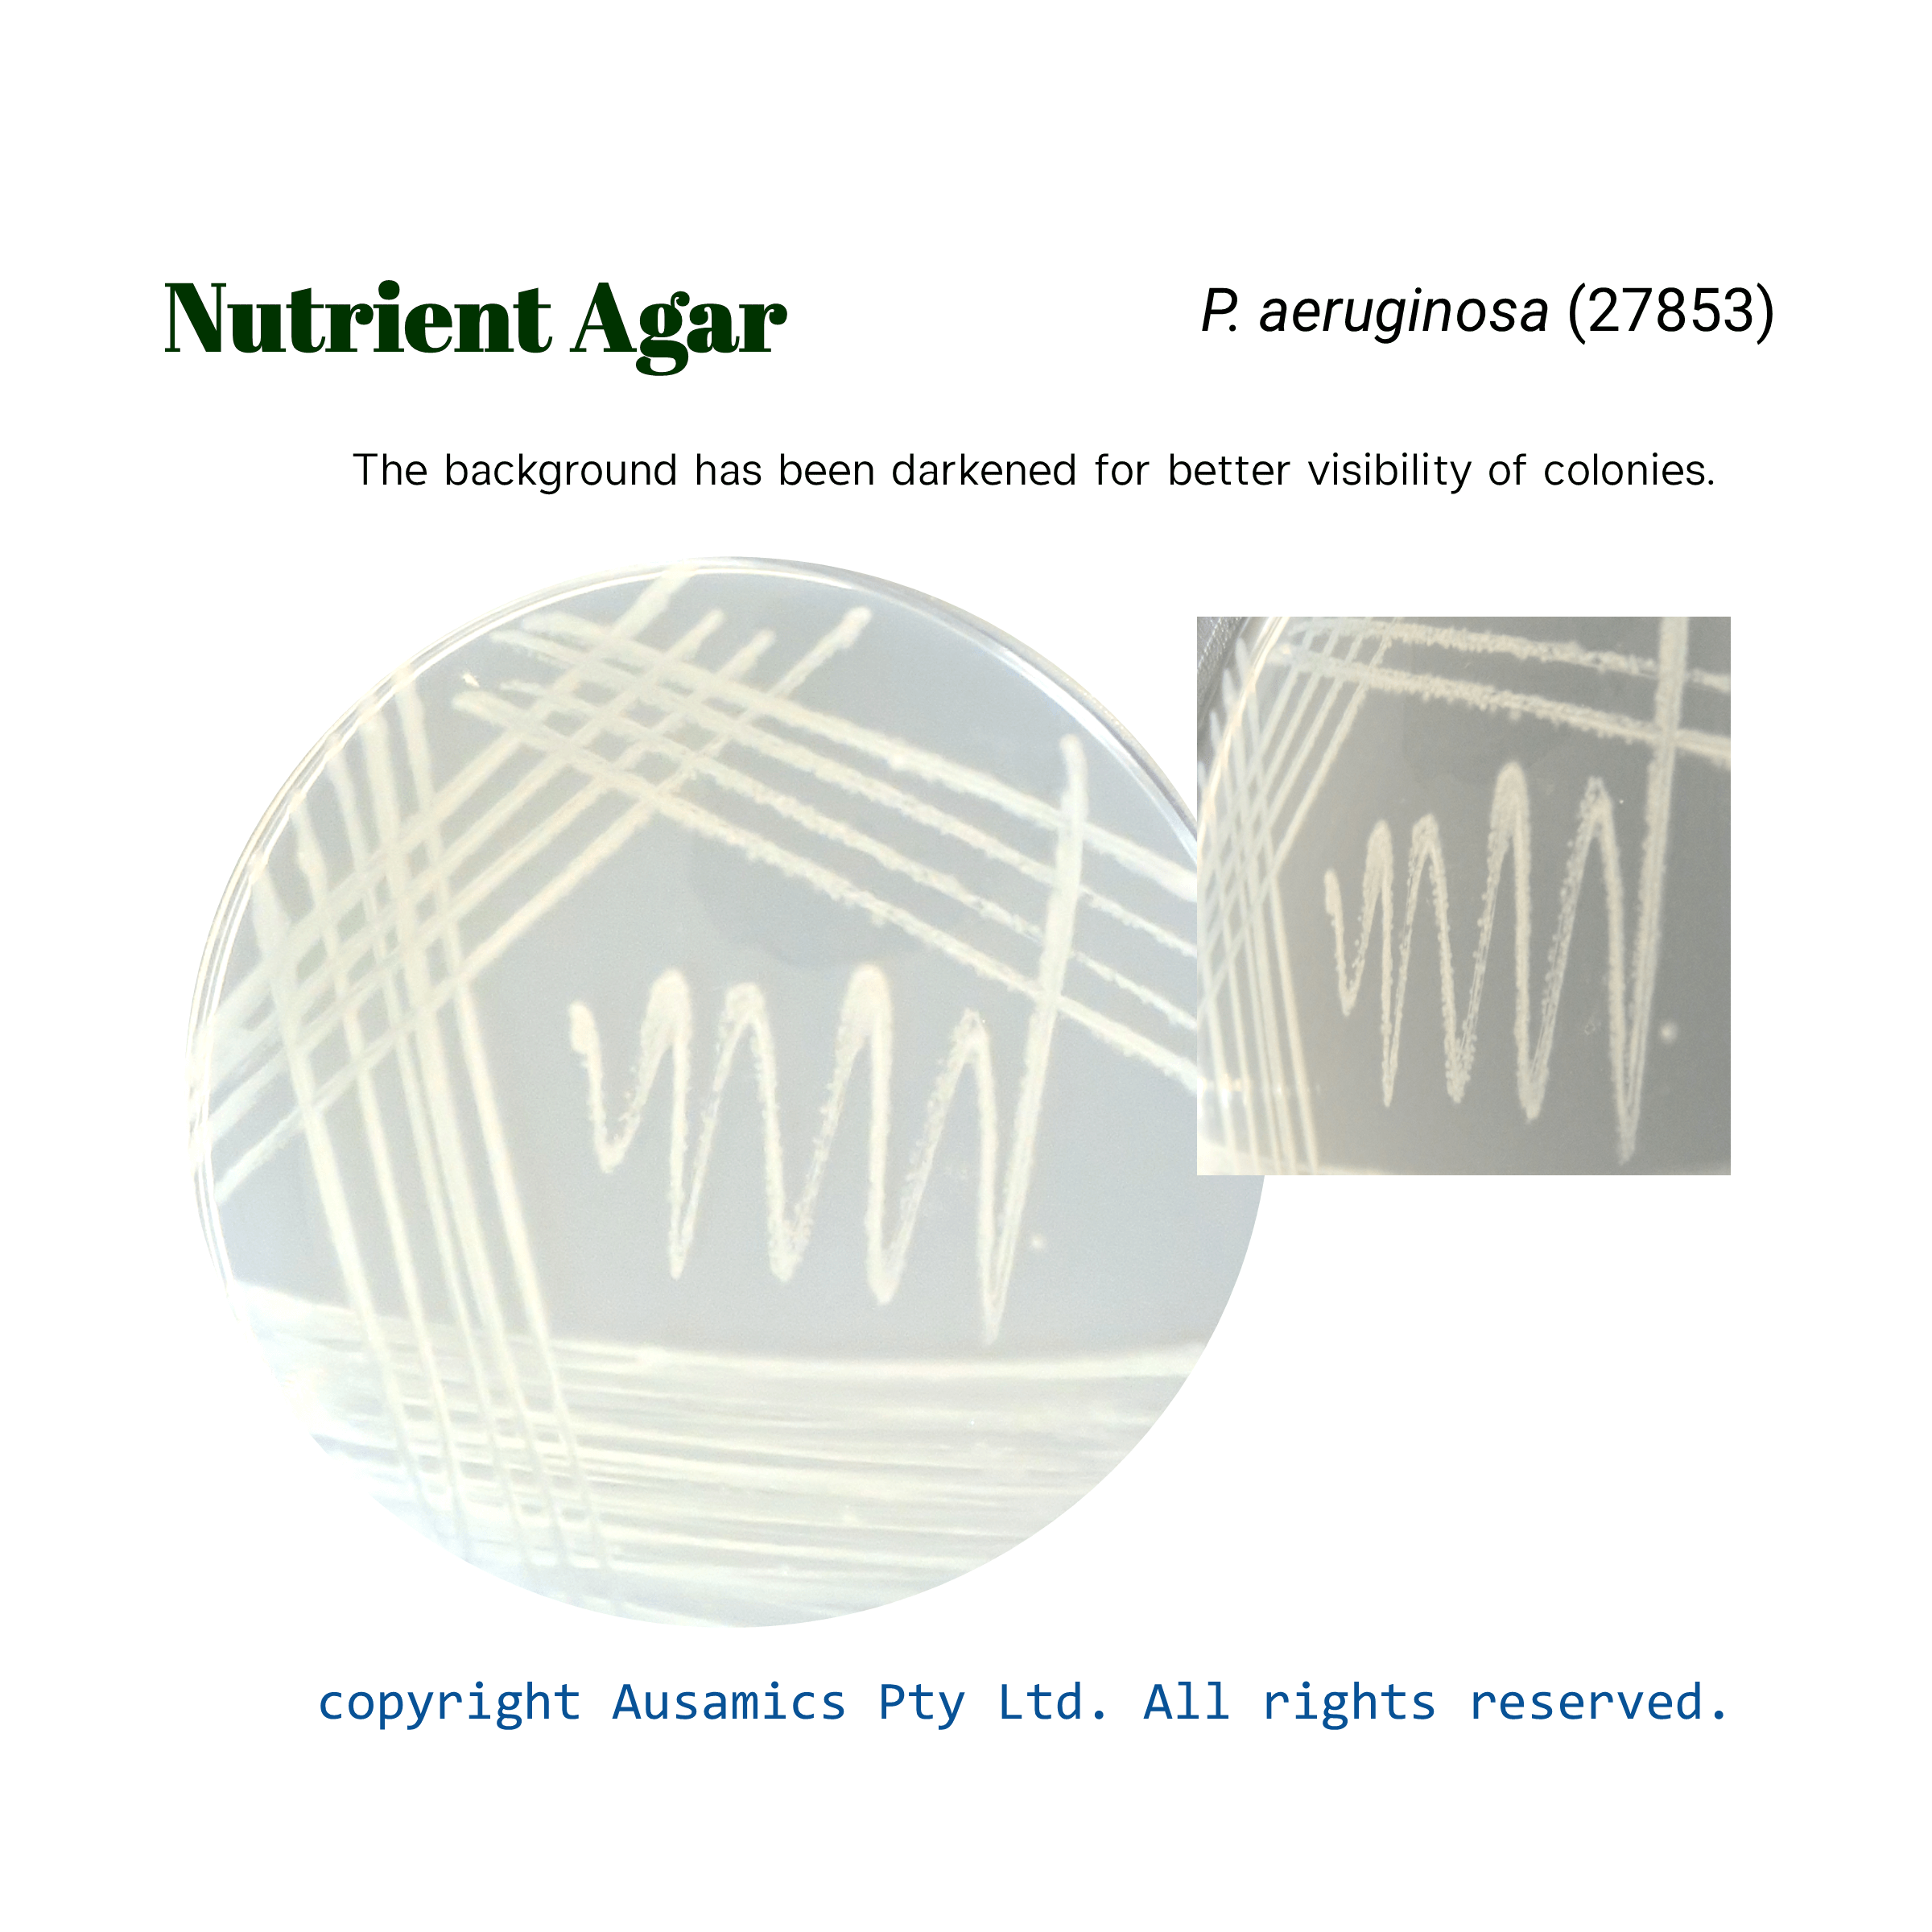

Nutrient Agar
For the cultivation and maintenance of a wide variety of microorganisms.
Category Microbial Culture Media
Catalog Number: AS-1307
- Description
- Composition
- Quality Control
- Microbial Test Results
Nutrient agar is a multipurpose culture medium that is reasonably easy to prepare and is meant for the cultivation and maintenance of non-fastidious microorganisms. It is frequently utilized in many different fields, including evaluating dairy and water quality. This medium gives a variety of microorganisms the vital nutrients they need. An essential component that provides amino acids, long-chain peptides, vitamins, and organic nitrogen compounds for microbial growth includes peptone, meat extract, and yeast extract. The medium gets solidified by bacteriological agar.
Storage
Keep the container at 15-30 °C and prepared medium at 2-8 °C.
| Composition | (gr/L) |
| Peptone | 5 |
| Beef Extract | 1 |
| Yeast Extract | 2 |
| Sodium Chloride | 5 |
| Agar | 15 |
| Final pH at 25°C | 7.4 ± 0.2 |
| Dehydrated Appearance | Tan, free-flowing, homogeneous. |
| Prepared Appearance | Light amber, very slightly to slightly opalescent. |
| Reaction of 2.8% Solution at 25°C | pH 7.4 ± 0.2 |
| For 18 to 48 hours, incubate at 35 ± 2°C. | |
| Organism (ATCC) | Recovery |
| Escherichia coli (25922) | Good |
| Enterococcus faecalis (19433) | Good |
| Pseudomonas aeruginosa (27853) | Good |